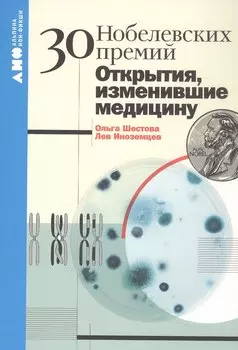
30 Нобелевских премий: Открытия, изменившие медицину

Вы находитесь на странице "пособия по написанию книги альпина паблишер". Здесь представлены товары российских и зарубежных компаний в количестве 20 шт., включая популярные мировые бренды. Доставка из интернет-магазинов возможна в такие города России как: Москва, Санкт-Петербург, Новосибирск, Екатеринбург, Казань, Нижний Новгород, Челябинск, Красноярск, Самара, Уфа, Ростов-на-Дону, Омск, Краснодар, Воронеж, Волгоград, Пермь и др. Каталог включает как доступные по цене товары, так и продукцию люксового сегмента.
-
 Альпина Паблишер1209 ₽824 ₽-31%
Альпина Паблишер1209 ₽824 ₽-31%Наука красоты: Косметика состоит из множества компонентов. Выбор подходящего средства, которое эффективно и безопасно, может быть сложным.
-
 Альпина Паблишер801 ₽625 ₽-21%
Альпина Паблишер801 ₽625 ₽-21%Лили учится считать. Книга помогает детям познакомиться с цифрами и научиться считать до 10 в игровой форме. Вместе с Лили дети узнают, зачем нужно уметь считать и что такое цифры.
-
 Альпина Паблишер1037 ₽809 ₽-21%
Альпина Паблишер1037 ₽809 ₽-21%Одиноки ли мы во Вселенной? Ведущие ученые мира о поисках инопланетной жизни | Если наша планета не уникальна, то вероятность повсеместного существования разумной жизни огромна. Более того, за всю ист...
-
 Альпина Паблишер1037 ₽809 ₽-21%
Альпина Паблишер1037 ₽809 ₽-21%Популяризация науки и научных коммуникаций активно развиваются. Для написания научно-популярных текстов не обязательно быть ученым, но важно следовать определенным правилам.
-
 Альпина Паблишер1179 ₽919 ₽-22%
Альпина Паблишер1179 ₽919 ₽-22%Голливудский стандарт: Как написать сценарий для кино и ТВ, который купят | Книга Майкла Хейга "Голивудский стандарт: Как написать сценарий для кино и ТВ, который купят" более 20 лет остается наиболее...
-
 Альпина Паблишер3303 ₽2575 ₽-22%
Альпина Паблишер3303 ₽2575 ₽-22%Сильный текст и деловая переписка: Книжный бокс Максима Ильяхова | Бокс упакован в брендированную подставку из плотного картона и пленку: он не повредится при транспортировке и его приятно дарить колл...
-
 Альпина Паблишер1238 ₽965 ₽-22%
Альпина Паблишер1238 ₽965 ₽-22%Изумительная Страна Снергов | Книга, вдохновившая Дж. Р.Р. Толкина! Пип и Флора в беде. Они убежали из приюта "Солнечная бухта" - и оказались в изумительной Стране Снергов. Это волшебная страна восхит...
-
Альпина Паблишер530 ₽413 ₽-22%
Альпина Паблишер530 ₽413 ₽-22%30 Нобелевских премий: Открытия, изменившие медицину | Самая известная и почетная в мире премия — Нобелевская — ежегодно присуждается за выдающиеся научные исследования, революционные изобретения, вкл...
-
![День зимнего солнцестояния. Правописание сложных слов]() Альпина Паблишер801 ₽625 ₽-21%
Альпина Паблишер801 ₽625 ₽-21%День зимнего солнцестояния. Правописание сложных слов | Сложные слова не просто так получили такое название. Действительно, научиться их правильно писать может быть очень не просто! В одних случаях ча...
-
![Говорящие с духами Мир сибирского шаманизма]() Альпина Паблишер884 ₽689 ₽-22%
Альпина Паблишер884 ₽689 ₽-22%Говорящие с духами Мир сибирского шаманизма | Во что верили коренные жители Сибири? Какие обряды и ритуалы они совершали? Как они представляли Вселенную? Кто такой шаман и зачем он пляшет с бубном у к...
-
![Я тебя прощаю: Как проработать семейные травмы и понять себя]() Альпина Паблишер435 ₽339 ₽-22%
Альпина Паблишер435 ₽339 ₽-22%Я тебя прощаю: Как проработать семейные травмы и понять себя | В родственных отношениях не избежать проблем и конфликтов. По разным причинам мы оказываемся неспособными подобрать нужные слова, выразит...
-
![Взаимная помощь. Почему мы эволюционируем, помогая друг другу]() Альпина Паблишер884 ₽689 ₽-22%
Альпина Паблишер884 ₽689 ₽-22%Взаимная помощь. Почему мы эволюционируем, помогая друг другу | Несмотря на то, что с момента написания работы «Взаимная помощь как фактор эволюции» прошло более ста лет, она по-прежнему актуальна. Пе...
-
![Уже смешно: Как писать комические тексты]() Альпина Паблишер825 ₽643 ₽-22%
Альпина Паблишер825 ₽643 ₽-22%Уже смешно: Как писать комические тексты | Книга «Уже смешно: Как писать комические тексты» — ваш путеводитель в мире комедии и юмора. Если вы задавались вопросом, как рассказывать шутки друзьям, как ...
-
![Менеджмент нового времени: Простые механизмы, ведущие к росту, инновациям и доминированию на рынке]() Альпина Паблишер1155 ₽901 ₽-21%
Альпина Паблишер1155 ₽901 ₽-21%Менеджмент нового времени: Простые механизмы, ведущие к росту, инновациям и доминированию на рынке | Это последняя книга одного из величайших гуру менеджмента XX века. Д-р Деминг вложил в нее весь сво...
-
![Напишите мою книгу! Все тонкости работы с наемным писателем]() Альпина Паблишер1179 ₽919 ₽-22%
Альпина Паблишер1179 ₽919 ₽-22%Напишите мою книгу! Все тонкости работы с наемным писателем | Кто такой наемный писатель — неудачник, продающий талант за деньги, или полноправный соавтор? Как пишутся книги на заказ и почему таких кн...
-
![Это ты мне? Как писать захватывающие диалоги для кино и сцены]() Альпина Паблишер1037 ₽809 ₽-21%
Альпина Паблишер1037 ₽809 ₽-21%Это ты мне? Как писать захватывающие диалоги для кино и сцены | - Учит, как средствами диалога раскрыть характер героя, сюжет повествования, его подтекст и предысторию. - Рассказывает, как сделать гол...
-
![Голливудский стандарт. Как написать сценарий для кино и ТВ, который купят]() Альпина Паблишер530 ₽413 ₽-22%
Альпина Паблишер530 ₽413 ₽-22%Голливудский стандарт. Как написать сценарий для кино и ТВ, который купят | Книга Майкла Хейга «Голивудский стандарт: Как написать сценарий для кино и ТВ, который купят» более 20 лет остается наиболее...
-
![Дайте жалобную книгу! Как заработать больше, используя обратную связь от клиентов]() Альпина Паблишер1037 ₽809 ₽-21%
Альпина Паблишер1037 ₽809 ₽-21%Дайте жалобную книгу! Как заработать больше, используя обратную связь от клиентов | Работа с обратной связью — бесплатный инструмент, который способен влиять на прибыль бизнеса. Урегулирование претенз...
-
![Менеджмент нового времени: Простые механизмы, ведущие к росту, инновациям и доминированию на рынке]() Альпина Паблишер580 ₽
Альпина Паблишер580 ₽Менеджмент нового времени: Простые механизмы, ведущие к росту, инновациям и доминированию на рынке | За свою долгую жизнь доктор Эдвардс Деминг, один из величайших гуру менеджмента XX века, написал мн...
-
![Из связей — в князи, или современный нетворкинг по-русски]() Альпина Паблишер385 ₽
Альпина Паблишер385 ₽Из связей — в князи, или современный нетворкинг по-русски | Просто поболтать с кем‑то или обменяться визитками — это еще не нетворкинг. Нетворкинг — это длительные дружеские отношения, на выстраивание...













